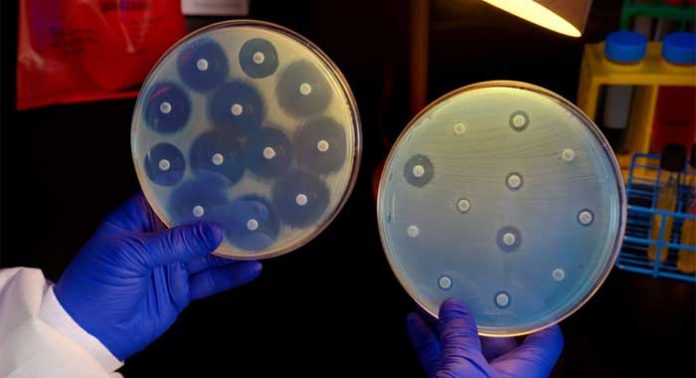

La amenaza de una era «post-antibiótica» se ha acercado más a la realidad, después de que el primer caso de resistencia al «último recurso» de antibióticos – colistina -, haya sido identificado en los Estados Unidos.
La colistina es un antibiótico polimixina producido por ciertas cepas de la bacteria Paenibacillus polymyxa var. colistinus. La colistina es una mezcla de polipéptido cíclico colistin A y B. La Colistina es efectiva contra todos los bacilos Gram-negativos y es usada como antibiótico polipéptido. Es una de las últimas armas contra las bacterias polirresistentes Pseudomonas aeruginosa, y Acinetobacter.
La resistencia a los antibióticos, o la resistencia a los antimicrobianos, se produce cuando los microorganismos desarrollan la capacidad de escapar de los efectos de las drogas que, una vez, tuvieron la capacidad de eliminarlas.
De acuerdo con los Centros para el Control y Prevención de Enfermedades (CDC), las infecciones resistentes a los antibióticos afectan a alrededor de 2 millones de personas en los EE.UU. cada año, y más de 23.000 personas mueren como resultado de estas infecciones.
Las enterobacterias – bacterias resistentes a carbapenem (ERC) se han convertido en una de las mayores amenazas para las infecciones resistentes a los antibióticos en los EE.UU., responsables de alrededor de 9.000 infecciones resistentes a los medicamentos cada año y 600 muertes.
Las ERC han desarrollado resistencia a casi todos los antibióticos disponibles, por lo que las infecciones por ERC son extremadamente difíciles de tratar. En algunos casos, estas «superbacterias» matan a casi la mitad de los pacientes que infectan.
La colistina es uno de los únicos antibióticos que todavía ha mostrado cierta eficacia contra las ERC, pero un nuevo informe sugiere que esto podría estar a punto de cambiar.
Gen mcr-1 resistente a colistina se encuentra en muestra de orina
En la revista Agentes Antimicrobianos y Quimioterapia, los investigadores del Instituto del Ejército Walter Reed de Investigaciones (WRAIR) y el Organismo Resistente a Múltiples Fármacos Repositorio y Vigilancia de Red (MRSN), revelan el primer caso de resistencia a la colistina en los EE.UU.
El informe revela que el mes pasado, una mujer de 49 años de edad se presentó en un centro militar de tratamiento en Pennsylvania con una infección del tracto urinario (ITU).
En pruebas de una muestra de orina de las mujeres, los investigadores encontraron que contenía una cepa de Escherichia coli – una especie de Enterobacteriaceae – que poseía un gen resistente a la colistina llamado mcr-1.
El gen MCR-1 surgió por primera vez en China, a finales del año pasado, identificado en un cerdo infectado con E. coli. El gen resistente a colistina ya se había encontrado en algunas partes de Europa y Canadá.
El caso que se detalla en el nuevo informe representa la primera vez que el gen mcr-1 se ha encontrado en los EE.UU.
¿Es esto el «final del camino» para los antibióticos?
Los funcionarios de salud creen que el descubrimiento es un motivo de preocupación; este gen resistente a los fármacos puede extenderse a otras bacterias, y si lo hace, podría significar el final de lo que ya es un antibiótico de último recurso.
El coautor del estudio, Dr. Patrick McGann, MRSN, WRAIR, comenta: «La colistina es uno de los últimos antibióticos eficaces para el tratamiento de bacterias altamente resistentes. La aparición de un gen transferible que confiere resistencia a este antibiótico vital es muy preocupante.
El descubrimiento de este gen en los EE.UU. es igualmente preocupante, y la vigilancia continua para identificar los reservorios de este gen dentro de la comunidad médica militar y más allá, es fundamental para evitar su propagación».
El Dr. McGann y sus colegas, dicen que el descubrimiento ha llevado a una «respuesta urgente de salud pública» para evitar la propagación de MCR-1, lo que implica una vigilancia activa de MCR-1 mediante la recopilación y análisis de muestras bacterianas.
«A través de nuestro sistema de vigilancia, tenemos la capacidad única para coordinar la información de origen con los datos de sensibilidad y de secuenciación, y si es necesario, volver a entender los cambios en los organismos infecciosos a mejor la infección a tratar y realizar un seguimiento de los organismos resistentes a múltiples fármacos emergentes», señala en el estudio como co-autor Emil Lesho, director de la MRSN y WRAIR.
En una entrevista, el director de los CDC, Dr. Tom Frieden, dijo que el nuevo informe muestra que el «final del camino no está muy lejos de los antibióticos», añadiendo que puede surgir la situación en la que un paciente con una infección urinaria ya no puede ser tratado.
«He estado allí para pacientes con TB [tuberculosis]. Me he preocupado de pacientes para los que ya no existen medicamentos opcionales», agregó. «Es un sentimiento de tal horror e impotencia. Esto no es donde tenemos que estar.»
resistencia bacteriana a los antibioticos, ultimo recurso contra bacterias gram






